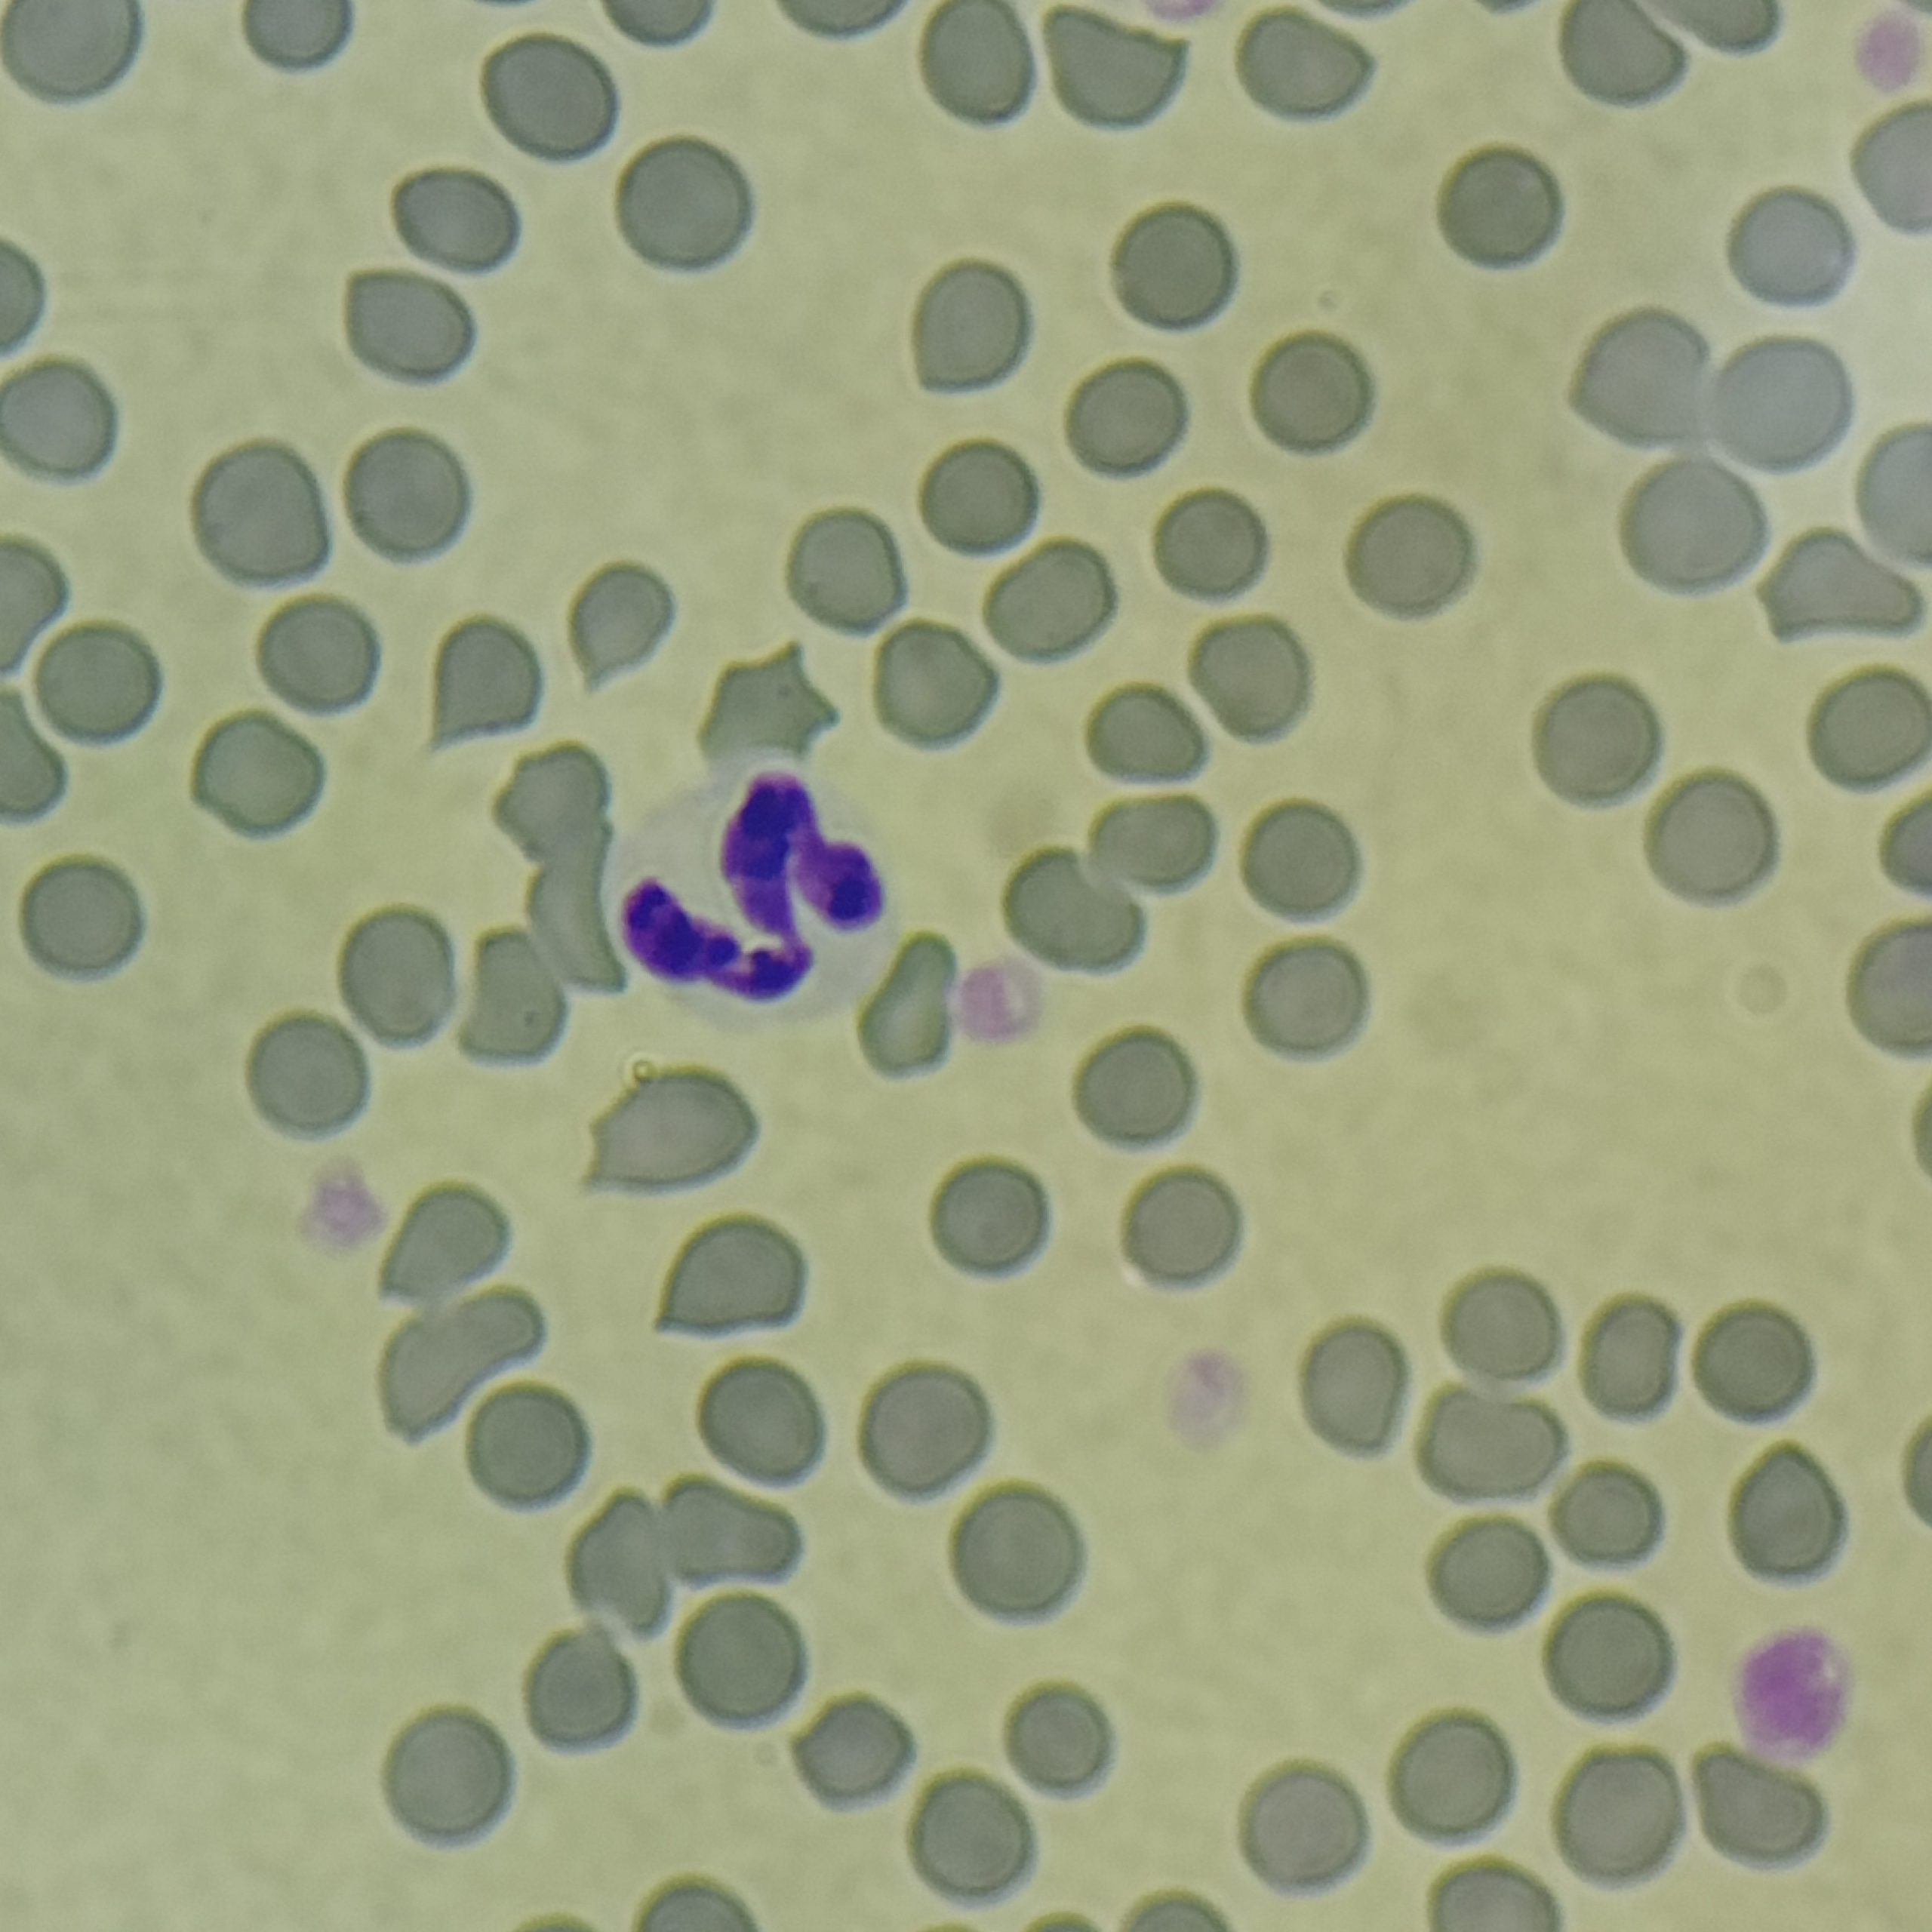

Biegunka u psa – co robić? 5 złotych zasad
Gdy pojawiają się problemy żołądkowe u psa, wielu opiekunów od razu zaczyna się martwić. Zrozumiałe jest,…

Podstawowe badanie diagnostyczne w weterynarii
Jedno z najczęściej wykonywanych badań laboratoryjnych w medycynie weterynaryjnej. Pozwala ocenić skład komórkowy krwi oraz wykryć wiele chorób na wczesnym etapie ich rozwoju.
Badanie polega na analizie liczby oraz wyglądu poszczególnych komórek: czerwonych krwinek, białych krwinek oraz płytek krwi. Dzięki temu lekarz weterynarii może ocenić ogólny stan zdrowia zwierzęcia, wykryć stany zapalne, infekcje lub choroby krwi.
Morfologia krwi jest często wykonywana zarówno w ramach rutynowej profilaktyki zdrowotnej u psa i kota, jak i w diagnostyce chorób wymagających dokładnej oceny funkcjonowania organizmu.
Badanie morfologiczne krwi jest jednym z podstawowych elementów diagnostyki weterynaryjnej i wykonywane jest w wielu sytuacjach klinicznych.
Najczęściej lekarz weterynarii zleca morfologię krwi:
Regularne badania krwi pozwalają wykryć wiele problemów zdrowotnych jeszcze zanim pojawią się wyraźne objawy kliniczne.
Badanie polega na pobraniu niewielkiej próbki krwi od zwierzęcia, najczęściej z żyły kończyny przedniej lub tylnej. Pobrana krew trafia następnie do laboratorium, gdzie analizowana jest przy użyciu specjalistycznych analizatorów hematologicznych.
W ramach morfologii oceniane są m.in.:
Dodatkowo wykonywany jest rozmaz krwi, który polega na mikroskopowej ocenie komórek na specjalnym preparacie. Pozwala to ocenić ich wygląd, proporcje oraz wykryć ewentualne nieprawidłowości w budowie komórek.
Ocena rozmazu krwi pozwala m.in.:
W większości przypadków zaleca się, aby zwierzę było na czczo przez około 8–12 godzin przed pobraniem krwi, ponieważ przyjmowanie pokarmu może wpływać na niektóre parametry laboratoryjne.
Przed badaniem warto również poinformować lekarza weterynarii o:
Samo pobranie krwi jest szybkie i zazwyczaj dobrze tolerowane przez zwierzęta.
Morfologia krwi z rozmazem dostarcza wielu informacji o stanie zdrowia psa lub kota i może pomóc w rozpoznaniu różnych chorób.
Badanie pozwala wykryć m.in.:
Badania krwi stanowią jeden z podstawowych elementów diagnostyki weterynaryjnej. Morfologia krwi z rozmazem pozwala szybko ocenić stan organizmu oraz dostarcza cennych informacji, które pomagają lekarzowi weterynarii w postawieniu trafnej diagnozy i zaplanowaniu dalszego leczenia.
Gdy pojawiają się problemy żołądkowe u psa, wielu opiekunów od razu zaczyna się martwić. Zrozumiałe jest,…
Kulawizna kończyny miednicznej u psa to objaw, którego nigdy nie warto ignorować. Czasem może być to…
Wymioty u psa to objaw, a nie rozpoznanie. Kiedy pies wymiotuje naturalną reakcją opiekunów jest niepokój.…